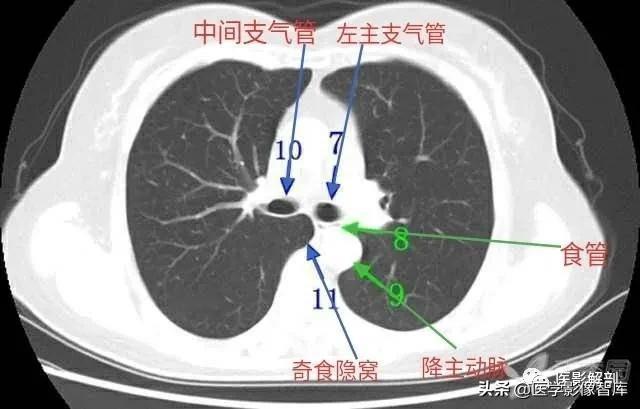

肺部CT解剖(高清图谱)
2024-11-14 18:07 来源:贴说网 点击:
肺部CT解剖(高清图谱)

来源:整理于“丁香园”
相关标签:
-
- 养金鱼过程中你不得不接触的鱼病之白点
-
2024-11-14 18:05:24
-
- 谢婷婷宣布产女,圈内未婚生子的明星,未婚妈妈还真不少
-
2024-11-14 18:03:08
-
- 外来媳妇本地郎康天庥大婚 众人合体现身 二嫂旁边的空位引人泪目
-
2024-11-14 18:00:52
-
- 太原十大律师事务所排名榜(房产继承咨询律师)
-
2024-11-14 17:58:36
-
- 什么是神仙豆腐树?哪里能够找到这种树?
-
2024-11-14 17:56:20
-
- 「iBeta 体验报告」iOS 12.4 Beta 6 发布,无肉眼可见更新
-
2024-11-12 21:21:46
-
- 肖战参加过天天向上哪几期的节目?
-
2024-11-12 21:19:30
-
- 我国南北自然地理分界线
-
2024-11-12 21:17:14
-
- 手机壁纸第18期:洛天依高清动漫壁纸,喜欢自取,记得点关注哦
-
2024-11-12 21:14:58
-
- 亲子头像 - 一家三口合影-温馨的一家人插画头像
-
2024-11-12 21:12:42
-
- 农村建房该建中式别墅,3款中式四合院,气势秒杀欧式小洋楼
-
2024-11-12 21:10:26
-
- 君君的魅力:连青筋都性感的越剧女神
-
2024-11-12 21:08:11
-
- 海贼王名刀科普:大快刀21工
-
2024-11-12 21:05:55
-
- SNH48姐妹团解散,大多数成员被公司安排当女主播
-
2024-11-12 21:03:39
-
- 睡觉一翻身木板床就咯吱响?看完才知道原来还能这样解决!赞赞赞
-
2024-11-12 21:01:23
-
- 清洁工捡获天价袜 袜子里暗藏玄机
-
2024-11-07 17:04:02
-
- 理工男自制雷神锤,太凶残了,满满的科技力量感
-
2024-11-07 17:01:46
-
- 抖音赞多了有钱拿吗?
-
2024-11-07 16:59:29
-
- 崇明长江隧道一货车撞击隧道墙面后侧翻
-
2024-11-07 16:57:13
-
- 白敬亭整容了吗 白敬亭整容前照片曝光
-
2024-11-07 16:54:57



后宫动漫排行榜前十名 让人羡慕嫉妒的后宫番
5本惊心动魄的民国潜伏国民党谍战文,蛰伏,是为了更好的进攻